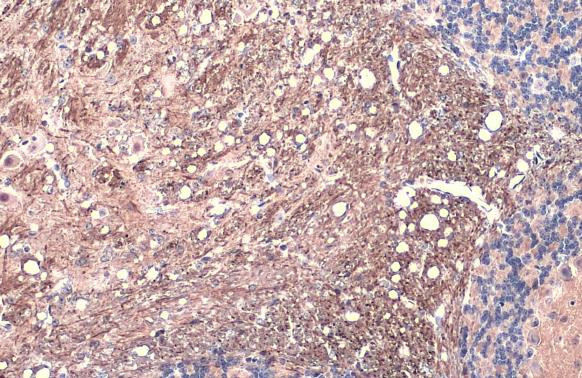
Phospho-Tau (Thr181) Antibody in Immunohistochemistry (Paraffin) (IHC (P))

Search
Invitrogen
Phospho-Tau (Thr181) Polyclonal Antibody
{{$productOrderCtrl.translations['antibody.pdp.commerceCard.promotion.promotions']}}
{{$productOrderCtrl.translations['antibody.pdp.commerceCard.promotion.viewpromo']}}
{{$productOrderCtrl.translations['antibody.pdp.commerceCard.promotion.promocode']}}: {{promo.promoCode}} {{promo.promoTitle}} {{promo.promoDescription}}. {{$productOrderCtrl.translations['antibody.pdp.commerceCard.promotion.learnmore']}}
产品信息
PA5-143364
种属反应
宿主/亚型
分类
类型
抗原
偶联物
形式
浓度
规格
纯化类型
保存液
内含物
保存条件
运输条件
RRID
产品详细信息
Store as concentrated solution.
Centrifuge briefly prior to opening vial.
靶标信息
Tau is a neuronal microtubule-associated protein found predominantly on axons. The function of Tau is to promote tubulin polymerization and stabilize microtubules. The C-terminus binds axonal microtubules while the N- terminus binds neural plasma membrane components, suggesting that tau functions as a linker protein between both. Axonal polarity is predetermined by TAU/MAPT localization (in the neuronal cell) in the domain of the cell body defined by the centrosome. The short isoforms allow plasticity of the cytoskeleton while the longer isoforms may preferentially play a role in its stabilization. In its hyper-phosphorylated form, Tau is the major component of paired helical filaments (PHF), the building block of neurofibrillary lesions in Alzheimer's diseases (AD) brain. Hyper-phosphorylation impairs the microtubule binding function of Tau, resulting in the destabilization of microtubules in AD brains, ultimately leading to the degeneration of the affected neurons. Numerous serine/threonine kinases phosphorylate Tau, including GSK-3beta, protein kinase A (PKA), cyclin-dependent kinase 5 (cdk5) and casein kinase II. Hyper-phosphorylated Tau is found in neurofibrillary lesions in a range and other central nervous system disorders such as Pick's disease, frontotemporal dementia, cortico-basal degeneration and progressive supranuclear palsy.
仅用于科研。不用于诊断过程。未经明确授权不得转售。
篇参考文献 (0)
生物信息学
蛋白别名: FLJ31424; FTDP17; G protein beta1/gamma2 subunit-interacting factor 1; map tau; MGC138549; Microtubule-associated protein tau; microtubules; Neurofibrillary tangle protein; neurofibrillary tangles; Neuronal Marker; Paired helical filament-tau; PHF-tau; PHFtau; protein phosphatase 1, regulatory subunit 103; Tau microtubule-associated protein; Tau-4; Tau-derived paired helical filament hexapeptide; Tau5; unnamed protein product
基因别名: AI413597; AW045860; DDPAC; FTD1; FTDP-17; MAPT; MAPTL; MSTD; Mtapt; MTBT1; MTBT2; PPND; PPP1R103; pTau; RNPTAU; TAU; tau-40; Tau-PHF6
UniProt ID: (Human) P10636, (Mouse) P10637
Entrez Gene ID: (Human) 4137, (Rat) 29477, (Mouse) 17762